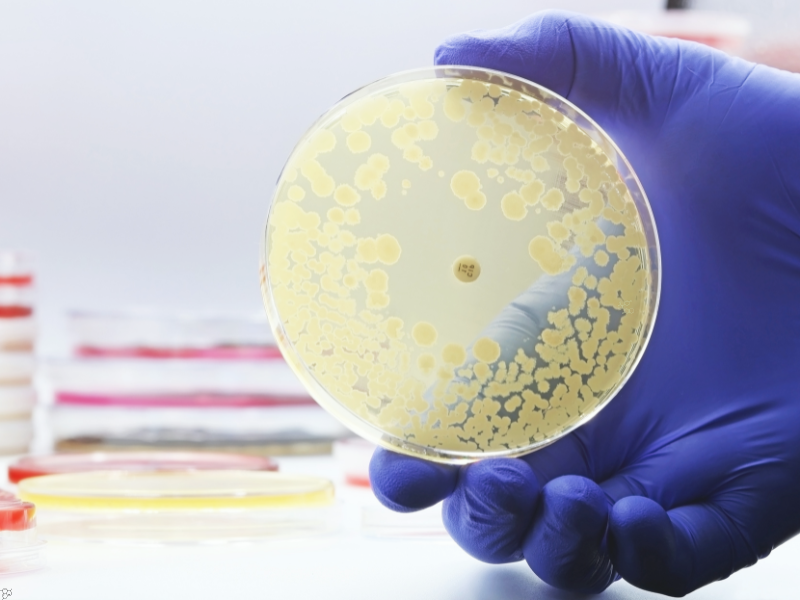

Lucy Shapiro received the Lasker Special Achievement Award for her discovery of how bacteria use genetic pathways to encode 3D cellular life. Her impressive 55 year career in biomedical sciences has reshaped the biopharmaceutical industry’s understanding of spatial organisation in bacterial cells.
Shapiro’s work centres on the bacterium Caulobacter crescentus. She has provided crucial insights into the ways genetic circuits of a cell determine its spatial dynamics. These dynamics, in turn, modulate genetic regulatory pathways.
She uncovered a vital hypothesis: How does linear DNA encode cells’ biochemical activities in three dimensions? Previously, scientists assumed that the DNA simply floated around in the bacterial cell. Shapiro, however, was confident that a logic existed, dictating how a cell decoded information about its 3D structure from its linear DNA.
To answer her question, she delved into the existing literature to find a simple cell that exhibited polarity and yielded two distinct daughter cells during division. When she landed on C. crescentus, a crescent-shaped bacterium with a flagellum on one end and a stalk-like appendage at the other.
Her lab demonstrated that bacterial genetic circuits do more than encode protein sequences: they regulate the spatial placement and timing of proteins, chromosomes, and cell-cycle regulators inside the cell.
She uncovered that bacterial cells are highly organised and found that chemoreceptor proteins which regulate bacterial chemotaxis in response to environmental cues, were confined to one pole of the cell. Furthermore, she found a gene encoding a response regulator, CtrlA, that controls the transcription of genes encoding important flagellar and chemotaxis proteins.
She discovered that swarmer cells contain CtrA, which gets degraded by proteases located at the cell pole during the swarmer-to-stalked cell transition. This reveals a delicate temporal and spatial organisation in the cells.
Her research led to the development of two FDA-approved drugs: one used as an antifungal and another to treat eczema. Ultimately, her career has contributed to founding systems biology, combining biology, engineering, and physics to understand how the internal spatial logic of cells works.